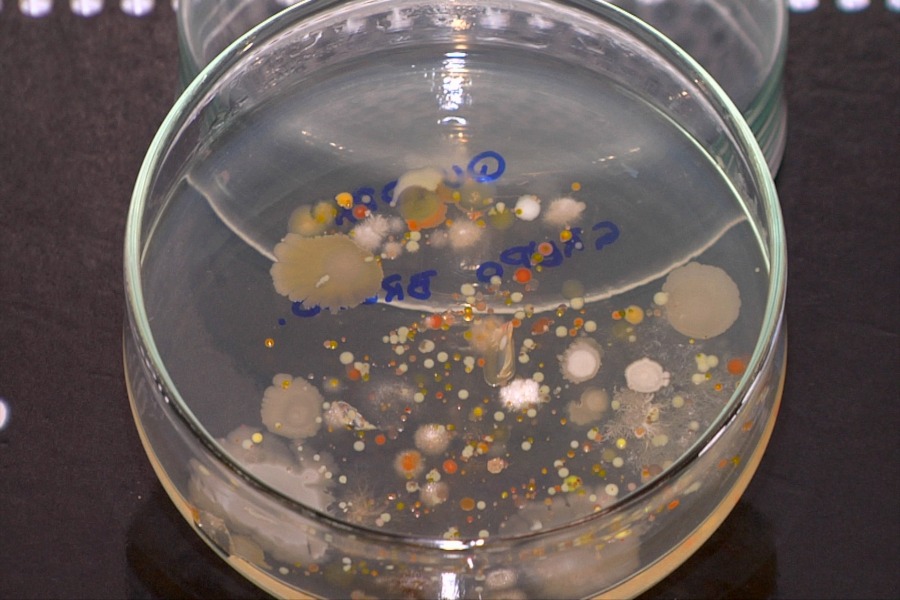

Evento busca aprofundar diálogo sobre temas na área de microbiologia

De 10 a 13 de setembro, acontecerá o “IV Simpósio em Microbiologia Agrícola: Desafios, fundamentos e aplicações” na Escola Superior de Agricultura “Luiz de Queiroz” (Esalq/USP). A atividade ocorrerá das 10h às 12h e das 14h às 18h, no auditório “Urgel Almeida Lima” (Jumbão) do Departamento de Agroindústria, Alimentos e Nutrição.
O simpósio será composto por minicursos, mesas redondas e palestras. O objetivo é aprofundar o diálogo e troca de experiências sobre temas importantes na área de microbiologia, buscando uma integração entre profissionais que atuam no setor acadêmico e em empresas do ramo.
As inscrições podem ser feitas pelo site http://fealq.org.br/en/informacoes-do-evento/?id=795
Mais informações: (19) 3447 8678 ou smagro.esalq@gmail.com